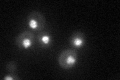
YGL201C
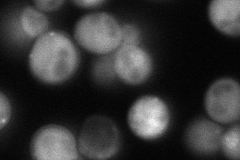
YGL201C
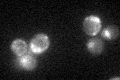
YGL201C

View description
Protein involved in DNA replication; component of the Mcm2-7 hexameric complex that binds chromatin as a part of the pre-replicative complex
Localization:
Intensity:
Fold change:
Significance:
-
C’ GFP library in SD
nucleus46.51 -
N' NOP1pr-GFP in SD
cytosol,punctate,nucleus116.437 -
N' TEF2pr-mCherry in SD

nucleus74.1088 -
N' NATIVEpr-GFP in SD

nucleus30.9756 -
N' TEF2pr-VC and Cyto-VN in SD

#N/A0 -
C’ GFP library in SD+DTT

nucleus30.510.65No -
C’ GFP library in SD+H2O2

nucleus48.961.05No -
C’ GFP library in Starvation Media
nucleus34.470.74No -
C’ GFP library on the background of Pup2-DaMP

nucleus -
C’ GFP library on the background of CCT mutant

nucleus58.05231.24783No
